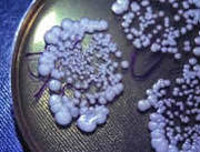

Как лечить кандидозный менингит
- Что такое Кандидозный менингит
- Что провоцирует Кандидозный менингит
- Патогенез (что происходит?) во время Кандидозного менингита
- Симптомы Кандидозного менингита
- Диагностика Кандидозного менингита
- Лечение Кандидозного менингита
- Профилактика Кандидозного менингита
- К каким докторам следует обращаться если у Вас Кандидозный менингит
Что такое Кандидозный менингит
Кандидоз является, прежде всего, эндогенной инфекцией. Кандиды могут заселять кожу, слизистую ротоглотки, кишечник, и транслокация их происходит через эпителий кишечника. При подобном варианте диссеминации, через кишечник, возникает инвазия кандидами, в первую очередь печени, селезенки, легких. Другие входные ворота для кандид – венозные катетеры. Инфицирование катетеров происходит с кожи больного или через руки медперсонала. При этом пути диссеминации грибов органами–мишенями становятся, как правило, почки, сердце, легкие. Циркуляция кандид в крови проходит непродолжительное время, затем, повреждая эндотелий, они внедряются в органы, приводя к образованию небольших абсцессов.
Инвазия дрожжевыми грибами центральной нервной системы протекает в виде поражения оболочек, вещества и сосудов головного мозга, нередко осложняя лечебный процесс у пациентов с вентрикуло–перитонеальными шунтами. Клинически проявляется менингитом, энцефалитом, абсцессами головного мозга, микотической аневризмой.
Поражение оболочек головного мозга характеризуется достаточно ярко выраженными общемозговыми и менингеальными симптомами, а также нейтрофильным или лимфоцитарным плеоцитозом в ликворе - в зависимости от степени нейтропении. Candida имеет низкую высеваемость из ликвора, при морфологическом исследовании ликвора друзы гриба или псевдомицелий обнаружить, как правило, не удается, клинические симптомы (лихорадка, головная боль) не специфичны, поэтому грибковая природа менингита у больных с нейтропенией редко распознается при жизни. Внутримозговые абсцессы, связанные с Candida, могут вызывать очаговую неврологическую симптоматику, соответствующую их локализации.
Кандидозный менингит характеризуется подострым или хроническим течением. Температура тела поднимается до 38°С. Больной малоподвижен и вял. Кожа бледная. Менингеальные симптомы выражены слабо или отсутствуют.
Иногда кандидозный менингит выявляют случайно у больных с судорожным синдромом и прогрессирующей гидроцефалией. Спинномозговая жидкость опалесцирующая, вытекает под давлением, повышено содержание белка.
Наиболее частыми и опасными осложнениями при менингитах являются инфекционно-токсический шок, острая надпочечниковая недостаточность, отек и набухание мозга. Гораздо реже регистрируются эпендиматит, гидроцефалия, лабиринтит, глухота, парезы и параличи.
Клинические проявления кандидозного менингита неспецифичны, а при морфологическом исследовании ликвора друзы грибков или псевдомицелий обнаружить не удается. Природа заболевания часто устанавливается посмертно.
Достоверным диагноз считается при лабораторном выделении дрожжеподобных грибков (из язвенных поражений слизистых оболочек, гноя, желчи, а при кандидозном сепсисе - из крови и пунктатов закрытых полостей). Важно обнаружение грибков в гистологических препаратах, полученных при прицельной биопсии, повторное выделении одного и того же вида грибков с открытой пораженной поверхности, их антигенов в сыворотке крови. Положительными считаются высокие титры (1:160-1:1600) или нарастание титров антител в ходе болезни.
Кандидозный менингит дифференцируют от бактериального менингита, генерализованный кандидоз - от генерализованной формы бактериальной инфекции.
Показания к терапии кандидозного менингита
Терапия показана при наличии следующих признаков:
• изменения в клиническом и/или биохимическом анализе спинномозговой жидкости, подтверждающие воспаление;
• выявление Candida spp. при микроскопии и/или посеве спинномозговой жидкости.
Лечение кандидозного менингита проводят вориконазолом (дозы – как при кандидемии) или амфотерицином В (1 мг/кг) или липосомальным амфотерицином В (5 мг/кг) или флуконазолом (400–800 мг). Из–за возможности рецидивов лечение следует проводить длительно, не менее 4 недель. Отменять антимикотики следует при условии стерилизации спинномозговой жидкости, ликвидации всех клинических проявлений инфекции, отсутствии поражения вещества головного мозга (контрольная МРТ).
Следует учитывать, что стерилизация спинномозговой жидкости наблюдается раньше эрадикации инфекционного поражения паренхимы головного мозга. Терапия кандидозного менингита, ассоциированного с нейрохирургическим лечением, включает удаление инородного материала (катетеров, шунтов) и назначение антимикотиков.
Длительность терапии: не менее 4 нед после исчезновения всех признаков инфекции.
Необходимо удаление контаминированных катетеров, шунтов и т.п. и коррекция внутричерепного давления.
В работах ряда исследователей продемонстированы преимущества профилактического применения флуконазола (Микосист).
Неоправданное профилактическое применение антимикотиков больным с низким риском кандидозного менингита не только бесполезно, но и вредно, поскольку может сопровождаться побочными эффектами и индуцировать селекцию штаммов Candida spp., рефрактерных к противогрибковым препаратам.
Менингит – это заболевание, которое характеризуется воспалением мозговых оболочек. Менингит провоцируется различными инфекциями: бактериями, вирусами, а также патогенными грибами. Грибковый менингит отличается медленным течением. Без должного лечения заболевание может вызывать тяжелые неврологические нарушения и даже летальный исход. При появлении признаков менингита следует обратиться за квалифицированной медицинской помощью. В Юсуповской больнице пациенту назначат необходимое обследование и подберут адекватную терапию. Врачи Юсуповской больницы имеют большой опыт эффективного лечения менингита, благодаря чему снижается риск развития осложнений.

Грибковый менингит: возбудители
При грибковом менингите причиной заболевания являются патогенные грибы различного рода. К наиболее часто вызывающим менингит относятся:
- грибы рода Candida;
- cryptococcus neoformans;
- coccidioides immitis.
Грибковый менингит обычно развивается на фоне иммунологических нарушений, хотя были случаи развития заболевания данного вида у практически здоровых людей. В группе риска заражения грибковым менингитом находятся люди со следующими заболеваниями:
- СПИД;
- хроническая почечная и печеночная недостаточность;
- саркоидоз;
- онкологические новообразования различной локализации;
- сахарный диабет;
- трансплантация органов.
С патогенными грибами человек контактирует практически каждый день, а некоторые, такие как Candida, являются частью его нормальной микрофлоры. При развитии заболеваний, отрицательно влияющих на иммунную систему, ослабляются функции защитного барьера организма. В результате грибковая инфекция проникает к мозговым оболочкам и вызывает их воспаление. При грибковом менингите происходит поражение мягких и твердых оболочек головного мозга, наблюдается их утолщение, на их поверхности появляются мелкие бугорки. Грибковый менингит является прогрессирующим заболеванием, которое может затрагивать мозговой ствол и распространяться на спинной мозг.

Согласно статистическим данным, грибковый менингит выявляется в 1–3 % случаев. Заболевание чаще имеет вирусный характер. Однако редкость не делает грибковый менингит менее опасной инфекционной патологией. Без корректного лечения летальный исход наступает в 70–80 % случаев. Поздняя обращаемость часто связывается с особенностью течения инфекционного заболевания. Для грибкового менингита не характерны выраженные менингеальные симптомы. Постепенное развитие заболевания ухудшает прогноз на выздоровление.
Основным методом диагностики менингита в Юсуповской больнице является люмбальная пункция. В полученном ликворе высевается возбудитель инфекции. В зависимости от патогенного микроорганизма врачи разрабатывают индивидуальный план лечения. Для каждого пациента подбирается терапия, объем которой зависит от особенностей течения болезни. Препараты соответствуют европейским стандартам качества и безопасности. Помимо терапевтических мероприятий, неврологи составляют реабилитационный план, ускоряющий процесс выздоровления. Грибковый менингит — не менее опасное инфекционное заболевание, чем вирусная форма. Врачи предупреждают, что самолечение может ускорить наступление летального исхода.
Грибковый менингит: симптомы у взрослых
Грибковый менингит может развиваться подостро и остро. У больных СПИДом заболевание иногда протекает бессимптомно или с минимально выраженными симптомами. К основным признакам развития грибкового менингита относят:
- повышение температуры тела;
- головную боль;
- сонливость;
- тошноту и рвоту.
Наиболее яркими признаками менингита являются лихорадка и головная боль. Сочетание этих двух симптомов позволяет заподозрить менингит. К основным симптомам могут присоединиться беспокойство, нарушение сна, парез черепно-мозговых нервов. Раздражительность и заторможенность также могут возникать во время менингита.
При грибковом менингите нередко развивается энцефалит. Он выявляется у половины пациентов с заболеванием, вызванным Coccidioides immitis. Расстройство сознания и психические нарушения отмечаются у пациентов с криптококковым и кандидозным менингитом.
Отличительной чертой грибкового менингита является отсутствие или слабая выраженность менингеального синдрома (ригидность шейных мышц, невозможность полностью разогнуть коленный сустав, непереносимость яркого света, резкая болезненность при пальпации нервов головы). Эта может сбить с толку пациента и задержать его обращение к врачу. Хорошо известно, что менингит имеет острое течение и его сложно спутать с другим заболеванием. Однако не в случае грибкового менингита. Вялое течение заболевания, постепенное нарастание симптоматики скрывает серьезность ситуации и не вызывает особых беспокойств. В этом и заключается коварство грибкового менингита. Для эффективного устранения заболевания необходимо начинать лечение как можно раньше. Поэтому необходимо не откладывать визит к врачу, даже если кажется, что ситуация под контролем.
Грибковый менингит: диагностика и лечение
Для своевременного выявления грибкового менингита важно вовремя обратиться за помощью. В Юсуповской больнице опытные врачи проведут обследование пациента и на основании клинической картины могут сделать определенные выводы. Уточнение диагноза выполняется с помощью анализа ликвора. Во время люмбальной пункции у пациента выполняют забор спинномозговой жидкости, из которой выделяют возбудителя. У большинства пациентов в ликворе обнаруживается лимфоцитарный плеоцитоз, который свидетельствует о развитии грибкового менингита.
Дополнительно пациенту могут назначить МРТ головного мозга для исключения сопутствующих заболеваний: туберкулеза, токсоплазмоза, церебральной опухоли. В Юсуповской больнице для диагностики грибкового менингита используются современные методы обследования, а также высокоточная аппаратура. Это позволяет диагностировать заболевание наиболее достоверно и в кратчайшие сроки.
Для лечения грибкового менингита применяют противогрибковые препараты и их сочетание. До получения данных о состоянии ликвора (на это необходимо время) терапию проводят эмпирически, а после получения результатов при необходимости выполняют корректировку назначений. При криптококковом и кандидозном менингите обычно используют амфотерицин В. При менингите, вызванном C. immitis, хорошо себя зарекомендовал флуконазол. Препараты вводят внутривенно или с помощью люмбальной пункции. В некоторых случаях используют сочетание данных препаратов для достижения требуемого терапевтического эффекта. Лечение противогрибковыми препаратами осуществляется долго – 1,5-2 месяца до полного выздоровления, что подтверждается контрольным анализом ликвора. Параллельно выполняется симптоматическая терапия: купирование рвоты, снижение внутричерепного давления, устранение судорожного синдрома.
Грибковый менингит: лечение в Москве
Лечение грибкового менингита в Москве успешно выполняют в Юсуповской больнице. Здесь работают квалифицированные неврологи и терапевты, которые имеют опыт лечения данного заболевания. Большой клинический опыт врачей позволяет заподозрить грибковый менингит на ранней стадии, что важно для своевременного начала лечения и исключения тяжелых осложнений. Неврологи Юсуповской больницы – это ведущие врачи России, доктора наук, которые берутся за самые сложные случаи и достигают максимального результата.
Лечение грибкового менингита проводится в условиях стационара. Для комфортного пребывания пациентов в Юсуповской больнице созданы все условия. Палаты оснащены удобной мебелью, широкоэкранным телевизором со спутниковым телевиденьем, высокоскоростным интернетом. Каждому пациенту предоставляется набор гигиенических средств, поэтому нет необходимости брать много вещей из дома. Уход за пациентами осуществляют квалифицированные медицинские сестры, которые смогут оказать необходимую помощь при любых изменениях в состоянии пациента.
В Юсуповской больнице пациенты получают медицинское обслуживание высшего качества. Чтобы получить информацию о работе клиники неврологии, записаться на прием к неврологу, терапевту и любому другому специалисту, можно позвонить по телефону Юсуповской больницы.

Грибковый менингит — поражение мягкой и твёрдой мозговых оболочек грибковой инфекцией с развитием воспалительных изменений. Клиническая картина характеризуется подострым/хроническим течением с повышением температуры, головной болью, сонливостью, слабой выраженностью оболочечных симптомов. Диагностировать грибковый менингит позволяет неврологический осмотр, проведение люмбальной пункции, анализ цереброспинальной жидкости, выявление возбудителя в крови и ликворе. Основу лечения составляют противогрибковые фармпрепараты, применяющиеся в качестве монотерапии, комбинированного и антирецидивного лечения.
МКБ-10

Общие сведения
Грибковый (микотический) менингит – редкая форма инфекционного поражения церебральных оболочек. Патология встречается повсеместно, уровень заболеваемости одинаков для лиц обоих полов. Грибковый менингит поражает преимущественно иммунокомпрометированных пациентов и людей, находящихся в эндемичных зонах распространения возбудителей. Среди больных СПИДом грибковый криптококковый менингит диагностируется в 6-13% случаев. В эндемических областях выявляется большое количество инфицированных грибком, однако лишь у 1% возникает диссеминация возбудителя, которая в 35% случаев сопровождается поражением мозговых оболочек.
Причины грибкового менингита
Возбудителями заболевания являются различные патогенные и условно патогенные грибы. Проникновение в организм осуществляется воздушно-капельным (при вдыхании грибковых спор), алиментарным (при употреблении обсеменённой спорами пищи, воды) путями. Больной человек не является источником инфекции для окружающих. Самыми часто встречающимися возбудителями менингита грибковой этиологии выступают:
- Криптококки. Наиболее распространенный возбудитель — C. Neoformans. Выделяется в окружающую среду с птичьим помётом, присутствует на овощах, фруктах, в почве. Заражение происходит с пищей, при вдыхании частичек пыли со спорами. Подавляющее число случаев заболевания представляют больные СПИДом.
- Кандиды. Относятся к естественной флоре человеческого организма. Вызывают развитие инфекционных заболеваний только на фоне иммунодефицита. Обусловленные этими грибами менингиты составляют 15% всех кандидозных поражений ЦНС.
- Кокцидии. Среди возбудителей кокцидиоза наиболее распространён С. Immitis. Микоз наблюдается в эндемичных регионах США, Южной и Центральной Америки. Поражение оболочек мозга происходит на фоне диссеминированной инфекции чаще у пожилых, беременных, больных с иммунной супрессией.
В группу риска развития микотического менингита любой этиологии попадают лица с иммунодефицитными состояниями: новорожденные, больные ВИЧ-инфекцией, перенёсшие цитостатическую терапию по поводу трансплантации органа, онкозаболевания, пациенты с ХПН, сахарным диабетом, алкоголизмом, заболеваниями крови, лица старше 60 лет.
Патогенез
Попав в организм, возбудитель сталкивается с реакцией защитных иммунологических факторов, препятствующих развитию инфекции. На фоне сниженного иммунного ответа грибковые споры не уничтожаются, током крови разносятся в различные органы и ткани, где происходит развитие возбудителя. Занос спор в оболочки мозга становится возможным в связи с повышенной проницаемостью гематоэнцефалического барьера, в норме обеспечивающего защиту мозговых тканей от проникновения циркулирующих в крови крупных молекул, в том числе различных инфекционных агентов.
Грибковый менингит сопровождается серозным воспалительным процессом. Происходит утолщение, помутнение оболочечных тканей, их поверхность приобретает мелкобугристый характер. Отмечаются петехиальные кровоизлияния. Воспалительный процесс может перейти на церебральное вещество с развитием энцефалита, на оболочки спинного мозга.
Классификация
В практической неврологии применяется разделение микотического поражения оболочек в зависимости от его уточнённой этиологии, особенностей клинического течения. В соответствии с видом возбудителя различают криптококковый, кандидозный, кокцидиозный, гистоплазменный, аспергиллёзный менингит. По течению заболевания грибковый менингит классифицируют на:
- Острый — характерно внезапное появление, быстрое развитие симптоматики. Встречается редко, преимущественно при кандидозной этиологии.
- Подострый — отличается замедленным дебютом с постепенно прогрессирующим нарастанием симптомов. Самый распространённый вариант. Впоследствии может переходить в хроническую форму.
- Хронический — симптоматика наблюдается более 4-х недель. Выраженность клинических проявлений умеренная.
Симптомы грибкового менингита
Начало заболевания обычно подострое (реже – острое), последующее течение хроническое. Основными симптомами становятся интенсивная головная боль (цефалгия), рвота, подъём температуры, анорексия, сонливость. У ряда пациентов цефалгия протекает с повторными, не приносящими облегчения рвотами. Температура тела держится на уровне 37,2-37,9 градусов, иногда достигает фебрильных значений. Отмечается потеря аппетита, возможно отвращение к пище. Больной вялый, много спит, быстро утомляется, выглядит заторможенным. Наблюдается повышенная чувствительность к свету. Возможны судорожные пароксизмы, беспокойство, расстройства сознания, очаговая симптоматика.
Отличительной особенностью является слабая выраженность менингеального синдрома, иногда — его полное отсутствие. Менингеальный симптомокомплекс — типичный признак поражения оболочек, включает напряжённость (ригидность) мышц затылка, специфическую позу больного, общую гиперестезию, тонические феномены, выявляемые в ходе осмотра. При подостром и хроническом течении грибковый менингит может не сопровождаться менингеальными симптомами, что значительно затрудняет диагностику.
Осложнения
В 40% случаев грибковый менингит протекает с внутричерепной гипертензией, усугубляющей цефалгию и вызывающей тошноту, рвоту. При распространении инфекционного процесса на спинальные оболочки возникает корешковый синдром, признаки поражения спинного мозга: периферические и центральные парезы, расстройства чувствительности. Переход инфекционно-воспалительного процесса на церебральные ткани сопровождается развитием очаговой симптоматики, тяжёлых нарушений сознания. Грибковый энцефалит опасен возникновением отёка головного мозга, комы, летальным исходом заболевания.
Диагностика
Диагностические сложности обусловлены стёртой симптоматикой, отсутствием ярко выраженного менингеального синдрома, наличием иммуносупрессии, затрудняющей иммунологическую диагностику заболевания. Постановка диагноза осуществляется с помощью следующих исследований:
- Неврологический осмотр.Невролог обращает внимание на наличие и степень выраженности менингеальной симптоматики, оценивает уровень сознания, выявляет очаговый неврологический дефицит, признаки поражения спинного мозга (если таковые имеются).
- Люмбальная пункция. Позволяет определить ликворное давление, оценить цвет, степень прозрачности ликвора. Последующее исследование цереброспинальной жидкости подтверждает лимфоцитарный плеоцитоз, уровень которого зависит от вида возбудителя, стадии болезни. Микроскопия мазков выявляет наличие нитей гриба в 50% случаев.
- МРТ головного мозга. Необходима для исключения сопутствующих церебральных поражений: туберкулёза, токсоплазмоза. Смешанная грибково-бактериальная, протозойно-грибковая инфекция встречается у иммунокомпрометированных больных.
- Лабораторные анализы. Направлены на верификацию возбудителя, определение его чувствительности к антимикотическим препаратам. Посев крови на стерильность, микробиологическое исследование ликвора позволяют исключить бактериальную этиологию, обнаружить рост грибковых колоний. Иммуноферментный анализ ликвора на наличие антимикотических антител по своей специфичности приближается к 100%, однако при иммунодефицитных состояниях может давать ложноотрицательные результаты.
Дифференциальная диагностика проводится с бактериальным менингитом, туберкулёзным менингитом, вирусным поражением оболочек. В ряде случаев требуется дифференцировка с менингиомой, абсцессом головного мозга, церебральной опухолью.
Лечение грибкового менингита
Основу терапии составляет применение антимикотических фармпрепаратов. До получения результатов определения чувствительности лечение проводится эмпирически, затем — с учётом полученных данных. Используются следующие варианты терапии:
- Монотерапия. Осуществляется путём медленного внутривенного капельного введения. При криптококковой этиологии, жизнеугрожающем кандидозном менингите до получения данных о чувствительности кокцидий показан амфотерицин В. В других случаях хорошо зарекомендовал себя флуконазол. При наличии показаний возможно интратекальное введение препарата посредством люмбальной или вентрикулярной пункции. Фармакотерапия осуществляется длительно (1,5-2,5 мес.) до полной санации ликвора.
- Комбинированное лечение. Проводится амфотерицином в сочетании с флуконазолом, флуцитозином. Данная разновидность терапии считается эффективной у пациентов с криптококковой инфекцией без сопутствующей клиники ВИЧ. Оптимальная комбинация препаратов пока не найдена.
- Противорецидивная терапия. Необходима для профилактики рецидива болезни даже в случае полной санации ликвора от возбудителя. Препаратом выбора выступает флуконазол.
Параллельно проводится симптоматическая терапия. Купирование рвоты достигается применением противорвотных средств, внутричерепное давление снижается мочегонными препаратами, лечение судорожного синдрома проводится антиконвульсантами.
Прогноз и профилактика
До внедрения в медицинскую практику амфотерицина грибковый менингит в 100% случаев приводил к летальному исходу. Сейчас своевременно начатая, правильно подобранная терапия позволяет сохранить пациенту жизнь, добиться его выздоровления. Прогноз болезни зависит от возраста, состояния иммунной системы, своевременности терапии, скорости санации ликвора в ответ на проводимое лечение. Рецидивирующий грибковый менингит наблюдается в 40% случаев. В случае выздоровления возможны остаточные явления в виде стойкого повышения интракраниального давления, эпилепсии, нарушений когнитивной сферы.
У 50% выживших новорожденных отмечается гидроцефалия, у 56% – задержка психического развития, что обусловлено самим заболеванием и токсическим побочным эффектом антимикотиков. Первичные профилактические мероприятия заключаются в осуществлении мер по укреплению иммунитета, предупреждению распространения ВИЧ. Вторичная профилактика сводится к мониторингу санации цереброспинальной жидкости, адекватному противорецидивному лечению.
Кандидозный менингит – это инфекционное воспалительное заболевание мягкой оболочки головного и спинного мозга, возбудителем которого является дрожжеподобный гриб из рода Кандиды, которое характеризуется появлением неврологической симптоматики, фотофобии (боязни света), головной боли и геморрагической сыпи по всему телу.
Распространение
Заболевание распространено во всех странах мира, но с большей частотой встречается в странах Центральной и Южной Африки (Нигер, Нигерия, Чад, Судан, Замбия, Намибия, Ботсвана, Ангола). Это связано с жарким климатом и нарушением жилищно-бытовых условий проживания и личной гигиены населения.
Причины
Возбудителем заболевания является дрожжеподобный гриб из рода Кандиды.
Причиной, по которой данная инфекция может попадать в головной и спинной мозг и провоцировать такое тяжелое заболевание, может служить лишь стойкое нарушение иммунной системы, которое ведет к резкому снижению иммунитета.
Это могут быть врожденные иммунодефицитные состояния, вызванные наследственными заболеваниями органов иммунной системы:
- синдром Незелофа – недостаточность выработки Т-лимфоцитов, клеток иммунной системы;
- синдром Ди-Джорджи – врожденное отсутствие вилочковой железы (тимуса) – органа, который отвечает за формирование иммунитета на первых годах жизни ребенка;
- синдром Чедиака-Хигаши - полное отсутствие нейтрофилов – клеток иммунной системы;
- синдром Веста – резкое снижение выработки иммуноглобулинов класса А (IgA).
Симптомы и локализация
Кандидозный менингит локализуется в мягкой оболочке спинного и головного мозга, а также в спинномозговой жидкости.
Симптомы кандидозного менингита:
Диагностика
Первичный осмотр осуществляется в приемном покое врачом-терапевтом или хирургом общей практики, далее после взятия общеклинических анализов такие больные без промедления доставляются, учитывая степень тяжести, в неврологический стационар или в реанимационное отделение и наблюдаются невропатологом, нейрохирургом, анестезиологом и терапевтом.
После уточнения диагноза серологическими или микробиологическими методами пациентов консультирует и дополняет уже назначенное лечение врач-инфекционист.
Лабораторные исследования:
- общий анализ крови, для которого характерно увеличение лейкоцитов до 25*10 9 /л (при норме 4-9*10 9 /л) и сдвиг лейкоцитарной формулы влево, увеличение СОЭ (скорости оседания эритроцитов) до 60 мм/ч при норме от 1 до 15 мм/ч. Данные изменения в анализе свидетельствуют о наличии тяжелого воспалительного процесса в организме;
- общий анализ мочи, в котором будут наблюдаться увеличение клеток плоского эпителия и лейкоцитов, свидетельствующих об остром воспалительном процессе в организме;
- анализ ликвора, который можно получить при спинномозговой или люмбальной пункции.
Спинномозговая пункция: больного просят лечь на бок и обхватить руками согнутые ноги для того чтобы позвоночник приобрел вид дуги и межпозвоночные пространства расширились. В место между 2 и 3 поясничным позвонком вкалывают раствор новокаина или лидокаина для обезболивания. Спустя 5 минут в место между позвонками вводят пункционную иглу на 3-4 см до попадания в полосное пространство.
Изменения показателей ликвора при кандидозном менингите
| Название показателя | Нормальное значение | Изменение при кандидозном менингите |
| Цвет и прозрачность | Бесцветная, прозрачная | Белесоватая, мутная |
| Скорость вытекания из пункционной иглы | 40 – 60 капель за 1 минуту | 90 – 110 капель за 1 минуту или струей |
| Давление | 130 – 180 мм вод. ст. | 250 – 500 мм вод.ст. |
| Цитоз (количество клеток в 1 мкл) | 2 – 8 | 250 – 700 и более, но не свыше 1000 |
| Лимфоциты | 90 – 95% | 80 – 100% |
| Нейтрофилы | 3 – 5% | 20 – 40 % |
| Белок | 160 – 330 мг/л | 1000 – 16000 мг/л |
| Глюкоза | 1,83 - 3,89 ммоль/л | 1,83 ммоль/л и ниже |
| Хлориды | 120 - 130 ммоль/л | 110 ммоль/л и ниже |
| Фибриновая пленка | Не образуется | Образуется |
Серологические исследования: выявление в сыворотке крови повышения титра специфических антител, вырабатываемых в ответ на инфицирование кандидозной инфекцией. Выбор иммунологических реакций при кандидозном менингите довольно большой и включает в себя:
- ПЦР (полимеразная цепная реакция);
- РА (реакция агглютинации);
- РНГА (реакция непрямой гемагглютинации);
- РСК (реакция связывания комплемента);
- ИФА (иммуноферментный анализ).
Микроскопическое исследование, материалом для которого является спинномозговая жидкость.
Лечение
Противогрибковые препараты:
- Амфолип по 400 ЕД на 1 кг массы тела 1 раз в сутки внутривенно капельно;
- Флуконазол (Микомакс, Нофунг) по 150 мг 2 раза в сутки.
Симптоматическое лечение:
- мочегонные препараты при повышенном внутричерепном давлении или при начинающемся отеке головного мозга – фуросемид по 40 мг в сутки внутривенно струйно;
- антиоксиданты – цитофлавин (витамин В2 и РР) внутривенно капельно 1 раз в сутки;
- физиологический раствор с растворенным дофамином или добутамином по 200 мл внутривенно капельно;
- альбумин или плазма по 100-150 мл внутривенно капельно;
- реополиглюкин по 200 мл внутривенно капельно;
- стофантин по 100 физиологического раствора внутривенно капельно.
Прогноз и осложнения
Для жизни прогноз сомнительный, так как кандидозный менингит редко встречается как самостоятельное заболевание, а развивается на фоне других болезней, которые резко снижают иммунитет. Вследствие таких патологических реакций в организме не редко (около 85%) наступает смертельный исход.
К другим осложнениям кандидозного менингита относятся:
- гидроцефалия;
- отек головного мозга;
- паралич конечностей;
- глухота;
- слепота;
- эпилепсия;
- расстройство личности;
- слабоумие.
Читайте также:


